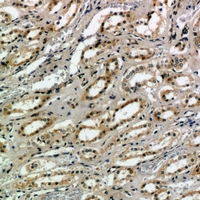
2 - Anti-CD159a/c Antibody AP54089

Anti-CD159a/c Antibody
- 产品详情
- 实验流程
- 背景知识
Application
| WB |
|---|---|
| Primary Accession | P26715 |
| Other Accession | P26717, Q07444 |
| Reactivity | Human, Mouse, Rat |
| Host | Rabbit |
| Clonality | Polyclonal |
| Calculated MW | 26314 Da |
| Gene ID | 3821 |
|---|---|
| Other Names | KLRC1; NKG2A; NKG2-A/NKG2-B type II integral membrane protein; CD159 antigen-like family member A; NK cell receptor A; NKG2-A/B-activating NK receptor; CD159a; KLRC2; NKG2C; NKG2-C type II integral membrane protein; CD159 antigen-like family member C; NK cell receptor C; NKG2-C-activating NK receptor; CD159c; KLRC3; NKG2E; NKG2-E type II integral membrane protein; NK cell receptor E; NKG2-E-activating NK receptor |
| Target/Specificity | KLH-conjugated synthetic peptide encompassing a sequence within the center region of human CD159a/c. The exact sequence is proprietary. |
| Dilution | WB~~1/500 - 1/1000 |
| Format | Liquid in 0.42% Potassium phosphate, 0.87% Sodium chloride, pH 7.3, 30% glycerol, and 0.09% (W/V) sodium azide. |
| Storage | Store at -20 °C.Stable for 12 months from date of receipt |
| Name | KLRC1 |
|---|---|
| Synonyms | NKG2A {ECO:0000303|PubMed:18083576} |
| Function | Immune inhibitory receptor involved in self-nonself discrimination. In complex with KLRD1 on cytotoxic and regulatory lymphocyte subsets, recognizes non-classical major histocompatibility (MHC) class Ib molecule HLA-E loaded with self-peptides derived from the signal sequence of classical MHC class Ia molecules. Enables cytotoxic cells to monitor the expression of MHC class I molecules in healthy cells and to tolerate self (PubMed:18083576, PubMed:37264229, PubMed:9430220, PubMed:9486650). Upon HLA-E-peptide binding, transmits intracellular signals through two immunoreceptor tyrosine-based inhibition motifs (ITIMs) by recruiting INPP5D/SHP-1 and INPPL1/SHP-2 tyrosine phosphatases to ITIMs, and ultimately opposing signals transmitted by activating receptors through dephosphorylation of proximal signaling molecules (PubMed:12165520, PubMed:9485206). Key inhibitory receptor on natural killer (NK) cells that regulates their activation and effector functions (PubMed:30860984, PubMed:9430220, PubMed:9485206, PubMed:9486650). Dominantly counteracts T cell receptor signaling on a subset of memory/effector CD8-positive T cells as part of an antigen-driven response to avoid autoimmunity (PubMed:12387742). On intraepithelial CD8-positive gamma-delta regulatory T cells triggers TGFB1 secretion, which in turn limits the cytotoxic programming of intraepithelial CD8-positive alpha-beta T cells, distinguishing harmless from pathogenic antigens (PubMed:18064301). In HLA-E-rich tumor microenvironment, acts as an immune inhibitory checkpoint and may contribute to progressive loss of effector functions of NK cells and tumor-specific T cells, a state known as cell exhaustion (PubMed:30503213, PubMed:30860984). |
| Cellular Location | Cell membrane; Single-pass type II membrane protein |
| Tissue Location | Predominantly expressed in NK cells (at protein level) (PubMed:20952657, PubMed:9430220, PubMed:9485206). Expressed in intraepithelial CD8-positive T cell subsets with higher frequency in gamma-delta T cells than alpha-beta T cells (at protein level) (PubMed:18064301). Expressed in memory gamma-delta T cells (at protein level) (PubMed:20952657). Restricted to a subset of memory/effector CD8-positive alpha-beta T cells (at protein level) (PubMed:12387742) Expressed in intratumoral NK and CD8-positive T cells (PubMed:30503213). Expressed in melanoma-specific cytotoxic T cell clones (at protein level) (PubMed:9485206). KLRD1-KLRC1 and KLRD1-KLRC2 are differentially expressed in NK and T cell populations, with only minor subsets expressing both receptor complexes (at protein level) (PubMed:20952657). |
Research Areas
For Research Use Only. Not For Use In Diagnostic Procedures.
Application Protocols
Provided below are standard protocols that you may find useful for product applications.
BACKGROUND
Rabbit polyclonal antibody to CD159a/c
终于等到您。ABCEPTA(百远生物)抗体产品。
点击下方“我要评价 ”按钮提交您的反馈信息,您的反馈和评价是我们最宝贵的财富之一,
我们将在1-3个工作日内处理您的反馈信息。
如有疑问,联系:0512-88856768 tech-china@abcepta.com.
¥ 1,500.00
Cat# AP54089























 癌症的基本特征包括细胞增殖、血管生成、迁移、凋亡逃避机制和细胞永生等。找到癌症发生过程中这些通路的关键标记物和对应的抗体用于检测至关重要。
癌症的基本特征包括细胞增殖、血管生成、迁移、凋亡逃避机制和细胞永生等。找到癌症发生过程中这些通路的关键标记物和对应的抗体用于检测至关重要。 为您推荐一个泛素化位点预测神器——泛素化分析工具,可以为您的蛋白的泛素化位点作出预测和评分。
为您推荐一个泛素化位点预测神器——泛素化分析工具,可以为您的蛋白的泛素化位点作出预测和评分。 细胞自噬受体图形绘图工具为你的蛋白的细胞受体结合位点作出预测和评分,识别结合到自噬通路中的蛋白是非常重要的,便于让我们理解自噬在正常生理、病理过程中的作用,如发育、细胞分化、神经退化性疾病、压力条件下、感染和癌症。
细胞自噬受体图形绘图工具为你的蛋白的细胞受体结合位点作出预测和评分,识别结合到自噬通路中的蛋白是非常重要的,便于让我们理解自噬在正常生理、病理过程中的作用,如发育、细胞分化、神经退化性疾病、压力条件下、感染和癌症。